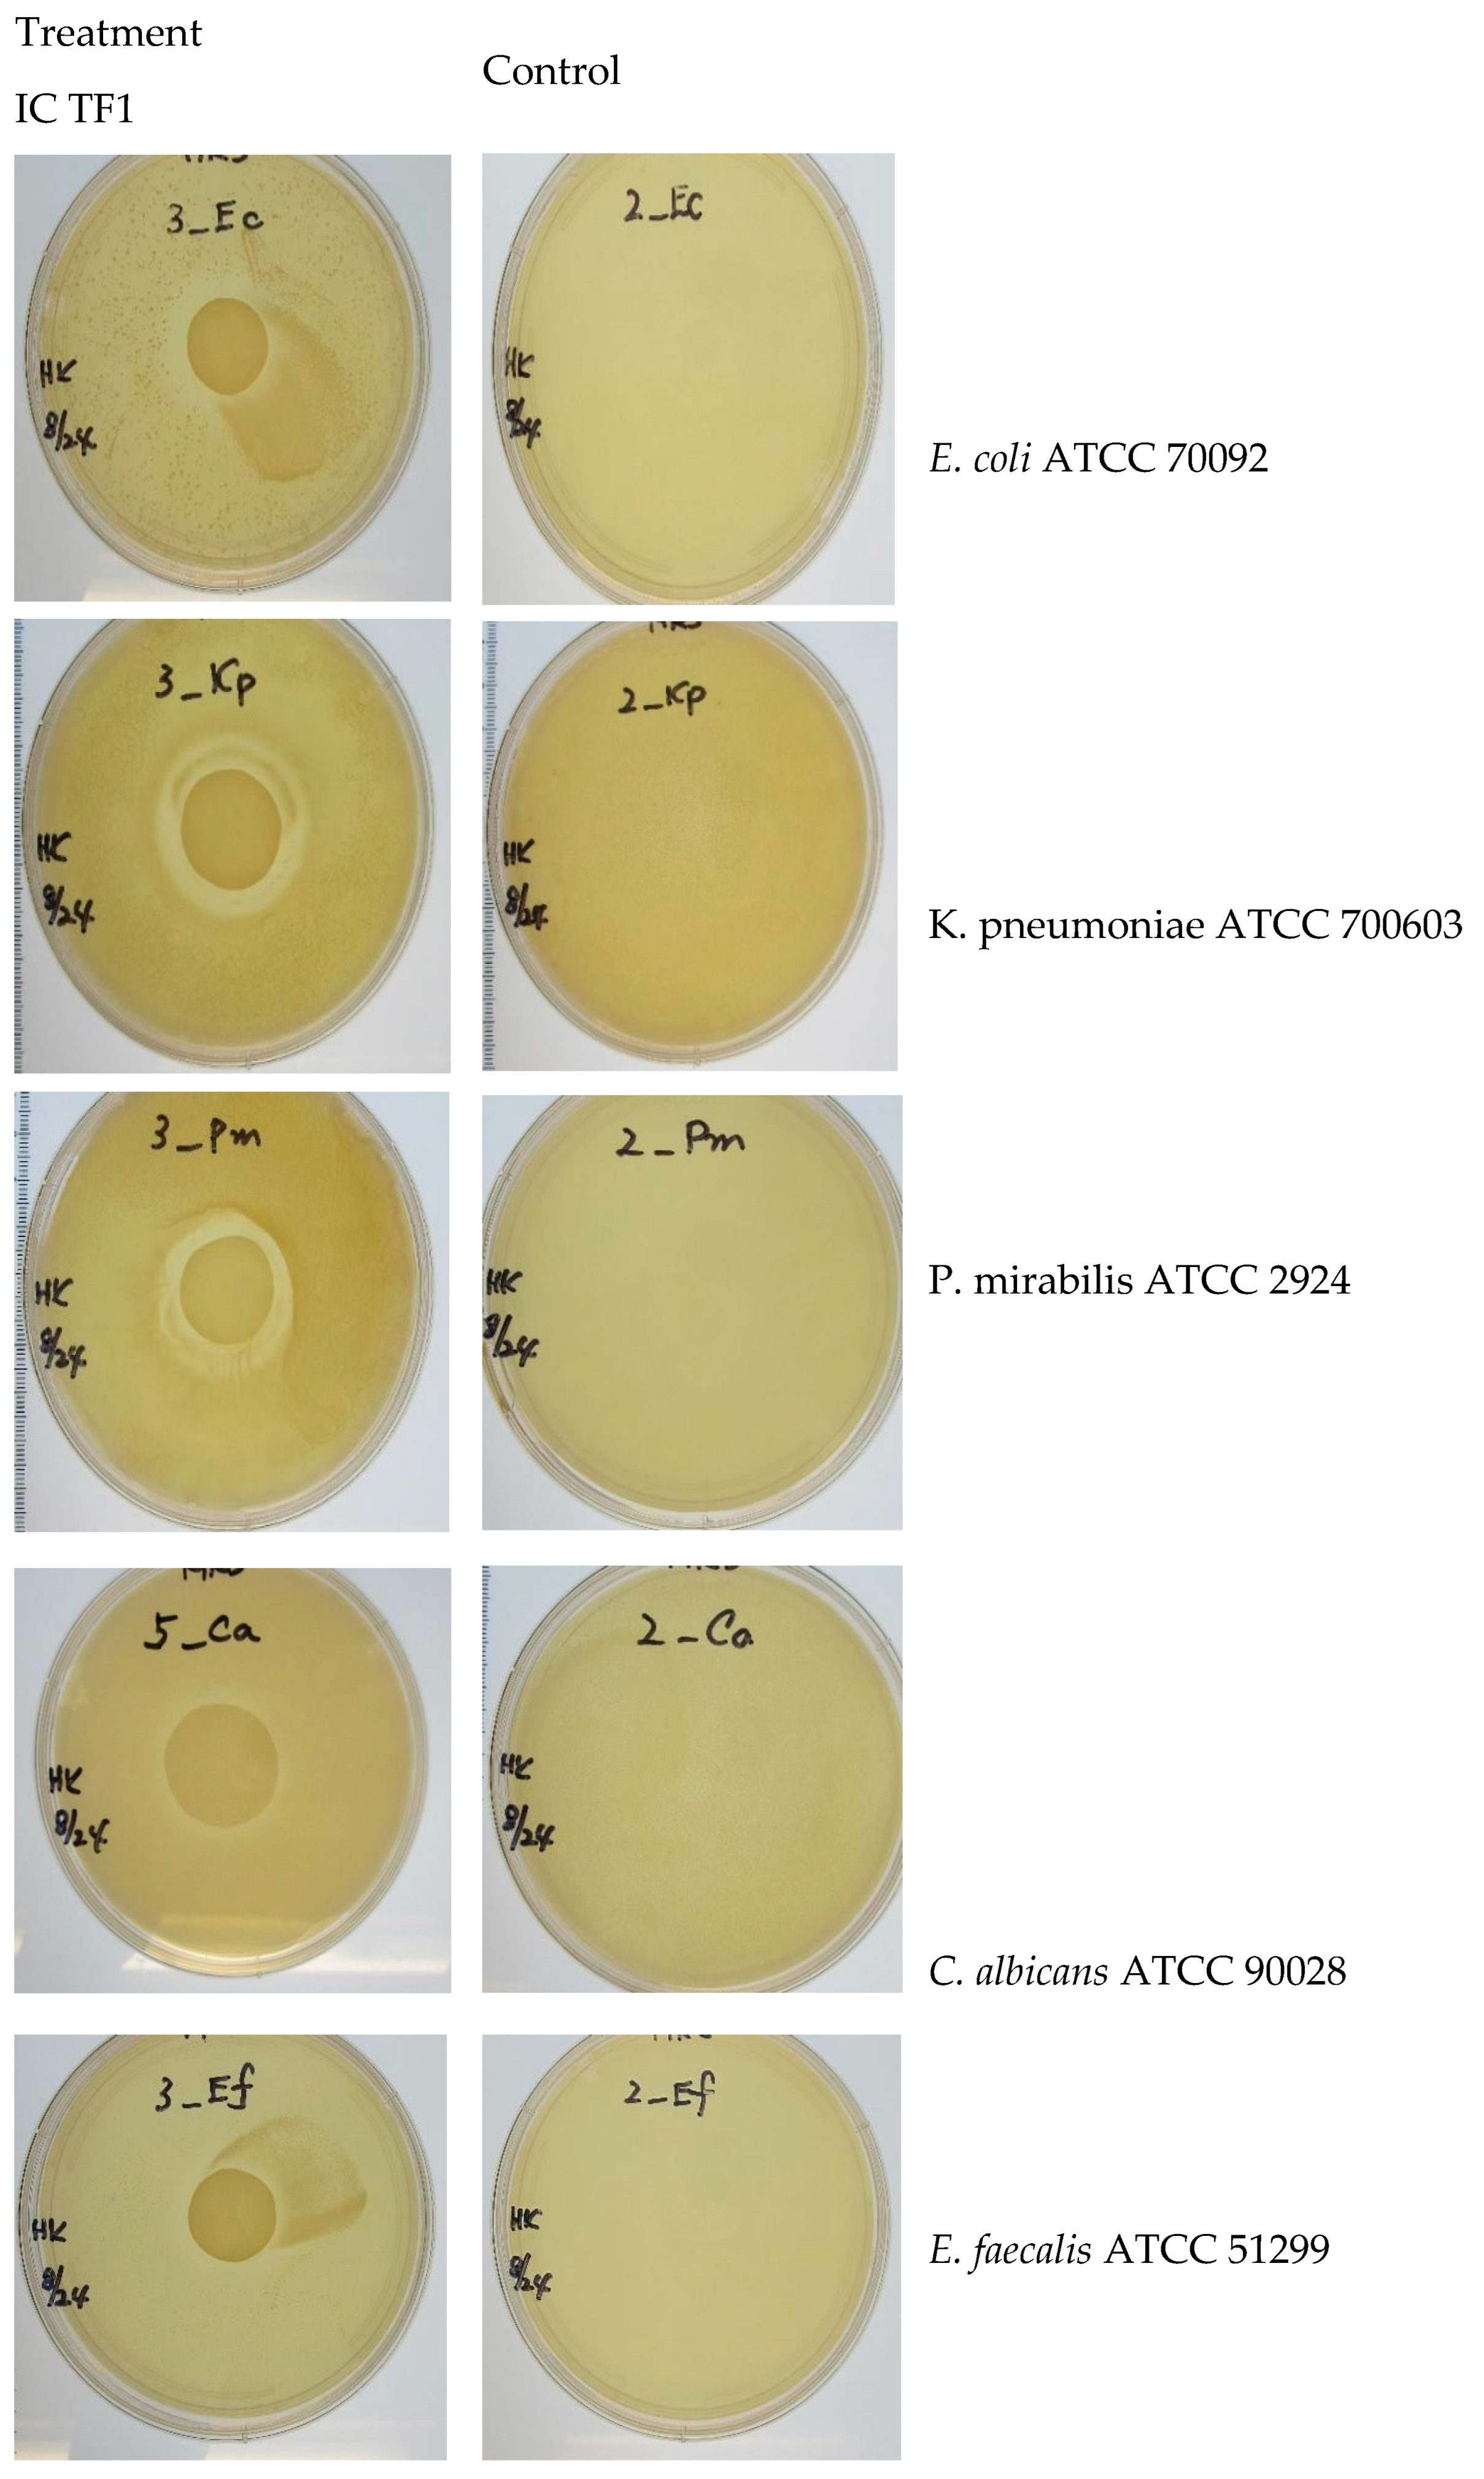

Submitted:
09 August 2024
Posted:
09 August 2024
You are already at the latest version
Abstract
Keywords:
1. Introduction
2.1. Materials
2.2. Culture Preparation
2.3. Porcine Tissue Procurement and Preparation
2.4. Methods Rationale
2.3. Method Description
2.3.1. Gelling Agent Preparation
2.3.2. IC TF1 Container Preparation
2.3.3. Sterilization, Packaging and Manufacturability
2.3.4. IC TF1 Catheter Lubricant Gel Preparation
2.3.5. hysical Properties of the IC TF1 Gel
Visual Appearance
pH
Viscosity
Osmolality
Lactobacillus assay in IC TF1 gel for Viability
The Effect of Temperature on IC TF1 Gel (“neat” as prepared)
Effect of Urine Media on Viability in IC TF1 Gel
2.3.6. Antimicrobial Activity
Agar Spot on Lawn (ASL) Method
2.3.7. Biocompatibility with Mouse Embryonic and Human Urethra Epithelial Cells
Direct Contact in Vitro Cytotoxicity Testing
2.3.8. Biocompatibility with Ex Vivo Porcine Bladder Tissue
3. Data Analysis
4. Storage and Sterility of Packaging
5. Results
5.1. Physical Properties of the IC TF1 Gel
pH
Viscosity
Osmolality
Distribution of Viable Lactobacilli Numbers at the Time of Preparation
The Effect of Temperature on Viable Lactobacilli in the IC TF1 Gel
The Effect of Urine Media on Viable Lactobacilli in IC TF1 Gel
5.2. Antimicrobial activity
5.3. Biocompatibility
-
Test 1: Direct Contact Cytotoxicity (Toxikon, MA)
- ○
- Cytotoxicity- L929 direct contact test—ISO 10993-5
- ○
- Test Article: Control gel (No Lactobacillus), HR Lubricating Jelly (commercial)
-
Test 2: Direct contact cytotoxicity testing (ISO 10993-5, modified without antibiotics) Integrated Pharma Services, MD
- ○
- Test Article: ICET, Inc. Gel Formulations, Commercial lubricants.
-
Test 3: Human urethral cell line direct cytotoxicity (ISO 10993-5, modified without antibiotics) Integrated Pharma Services,
- ○
- Test Article: ICET Gel Formulation, Commercial lubricants.
5.4. The influence of storage of IC TF1 kit.
6. Discussion
Clinical Implications and Future Directions
7. Conclusions
Funding
Data Availability Statement
Conflicts of Interest
References
- Manack A, Motsko SP, Haag-Molkenteller C, et al. Epidemiology and healthcare utilization of neurogenic bladder patients in a US claims database. Neurourol Urodyn. 2011; 30:395–401. [CrossRef]
- Jain NB, Ayers GD, Peterson EN, Harris MB, Morse L, et al. Traumatic spinal cord injury in the United States, 1993-2012. JAMA 2015; 313:2236-43. [CrossRef]
- Lee BB, Cripps RA, Fitzharris M, Wing PC. The global map for traumatic spinal cord injury epidemiology: update 2011, global incidence rate. Spinal Cord 2014; 52:110–6.
- Stoffel, John T. (2016). “Detrusor sphincter dyssynergia: a review of physiology, diagnosis, and treatment strategies”. Translational Andrology and Urology. 5 (1): 127–135.
- Groah S, Perez-Losada M, Caldovic L, et al. MP20–08 pyuria and asymptomatic bacteriuria is associated with novel and specific urine microbiomes. J Urol 2015; 193: e226. [CrossRef]
- Groah SL. Neurogenic bladder and the urine microbiome: the good, the bad and the ugly. Presented at the American Spinal Injury Association Annual Meeting, April 2017, Albuquerque, NM.
- https://clinicaltrials.gov/study/NCT04373512?term=Suzanne%20Groah&rank=2.
- Groah SL, Pérez-Losada M, Caldovic L, et al. Redefining Healthy Urine: A Cross-Sectional Exploratory Metagenomic Study of People with and Without Bladder Dysfunction. J Urol. 2016 Aug;196(2):579-587. [CrossRef]
- Tractenberg, R.E., Groah, S.L., Frost, J.K., Rounds, A.K., Davis, E., Ljungberg, I.H. and Schladen, M.M. (2021), Effects of Intravesical Lactobacillus spp. on Urinary Symptom Burden in People with Neurogenic Lower Urinary Tract Dysfunction. PM&R, 13: 695-706. [CrossRef]
- Groah S, Ljungberg I, Tractenberg R, et al. Self-Management of Urinary Symptoms Using a Probiotic in People with Spinal Cord Injuries, Spina Bifida, and Multiple Sclerosis [Internet]. Washington (DC): Patient-Centered Outcomes Research Institute (PCORI); 2020 Dec.
- Tractenberg, R.E., Frost, J.K., Yumoto, F. et al. Reliability of the Urinary Symptom Questionnaires for people with neurogenic bladder (USQNB) who void or use indwelling catheters. Spinal Cord 59, 939–947 (2021). [CrossRef]
- Tractenberg, R.E., Groah, S.L., Rounds, A.K., Davis, E.F., Ljungberg, I.H., Frost, J.K. and Schladen, M.M. (2021), Clinical Profiles and Symptom Burden Estimates to Support Decision-Making Using the Urinary Symptom Questionnaire for People with Neurogenic Bladder (USQNB) using Intermittent Catheters. PM&R: The Journal of Injury, Function and Rehabilitation, 13: 229-240. [CrossRef]
- Forster CS, Hsieh MH, Pérez-Losada M, Caldovic L, Pohl H, Ljungberg I, Sprague B, Stroud C, Groah S. A single intravesical instillation of Lactobacillus rhamnosus GG is safe in children and adults with neuropathic bladder: A phase Ia clinical trial. J Spinal Cord Med. 2021 Jan;44(1):62-69. [CrossRef]
- Brooks, T and Keevil, CW. A simple artificial urine for the growth of urinary pathogens. Letters in Applied Microbiology 1997, 24, 203–206. [CrossRef]
- Anderson, M.J., Parks, P.J., and M. L. Peterson. A mucosal model to study microbial biofilm development and antibiofilm therapeutics. J. Micro. Methods 2013 Feb 15;92(2):201-8. [CrossRef]
- Anderson, M.J., Scholz, M.T., Parks, P.J., and M. L. Peterson Ex vivo porcine vaginal mucosal model of infection for determining effectiveness and toxicity of antiseptics. J. Applied Microbiol. 2013 Sep;115(3):679-88.
- Anderson, M.J., David, M.L., Scholz, M., Bull, S.J., Morse, D., Hulse-Stevens, M., and M. L. Peterson. Efficacy of Skin and Nasal Povidone-Iodine Preparation against mupirocin resistant MRSA and Staphylococcus aureus within the anterior nares. Antimicrob. Agents Chemother. 2015 May; 59(5):2765-73.
- Parsons BA, Drake MJ, Gammie A, Fry CH, Vahabi B. The validation of a functional, isolated pig bladder model for physiological experimentation. Front Pharmacol. 2012 Mar 30;3:52. [CrossRef]
- Lucas E. Medical Management of Neurogenic Bladder for Children and Adults: A Review. Top Spinal Cord Inj Rehabil. 2019 Summer; 25(3):195-204. [CrossRef]
- Lee B, Haran M, Hunt L, Simpson J, Marial O, Rutkowski S, et al. Spinal-injured neuropathic bladder antisepsis (SINBA) trial. Spinal Cord. 2007; 45:542–50. [CrossRef]
- Morton SC, Shekelle PG, Adams JL, Bennett C, Dobkin BH, Montgomerie J, et al. Antimicrobial prophylaxis for urinary tract infection in persons with spinal cord dysfunction. Arch Phys Med Rehabil. 2002; 83:129–38. [CrossRef]
- Toh SL, Boswell-Ruys CL, Lee BSB, Simpson JM, Clezy KR. Probiotics for preventing urinary tract infection in people with neuropathic bladder. Cochrane Database Syst Rev. 2017;9 CD010723.
- Falagas ME, Betsi GI, Tokas T, Athanasiou S. Probiotics for prevention of recurrent urinary tract infections in women. Drugs. 2006; 66:1253–61. [CrossRef]
- Oerlemans, E.F.M., Bellen, G., Claes, I. et al. Impact of a Lactobacilli-containing gel on vulvovaginal candidosis and the vaginal microbiome. Sci Rep 10, 7976 (2020). [CrossRef]
- Cohen CR, Wierzbicki MR, French AL, Morris S, Newmann S, Reno H, Green L, Miller S, Powell J, Parks T, Hemmerling A. Randomized Trial of Lactin-V to Prevent Recurrence of Bacterial Vaginosis. N Engl J Med. 2020 May 14;382(20):1906-1915.
- Asahara T, Nomoto K, Watanuki M, Yokokura T. Antimicrobial activity of intraurethrally administered probiotic Lactobacillus casei in a murine model of Escherichia coli urinary tract infection. Antimicrob Agents Chemother. 2001 Jun;45(6):1751-1760.
- Groah SL, Rounds AK, Pérez-Losada M. Intravesical Lactobacillus rhamnosus GG Alters Urobiome Composition and Diversity Among People with Neurogenic Lower Urinary Tract Dysfunction. Top Spinal Cord Inj Rehabil. 2023 Summer;29(3):44-57. [CrossRef]
- Dauw CA, Wolf JS. Fundamentals of urinary tract drainage. In: Partin AW, Dmochowski RR Kavoussi LR, Peters CA, eds. Campbell-Walsh-Wein Urology. 12th ed. Philadelphia, PA: Elsevier; 2021: chap 12.
- World Health Organization. (2012). Use and procurement of additional lubricants for male and female condoms: WHO/UNFPA/FHI360: advisory note. World Health Organization.
- Caballero-Flores, G., Pickard, J.M. & Núñez, G. Microbiota-mediated colonization resistance: mechanisms and regulation. Nat Rev Microbiol 21, 347–360 (2023). [CrossRef]
- Lebeer, S., Verhoeven, T., Claes, I., De Hertogh, G., Vermeire, S., Buyse, J., Van Immerseel, F., Vanderleyden, J. and De Keersmaecker, S. (2011), FISH analysis of Lactobacillus biofilms in the gastrointestinal tract of different hosts. Letters in Applied Microbiology, 52: 220-226.
- Fouts, D.E., Pieper, R., Szpakowski, S., Pohl, H., Knoblach, S., Suh, M., Huang, S., Ljungberg, I., Sprague, B.M., Lucas, S.K., Torralba, M., Nelson, K.E., Groah, S.L. (2012). Integrated next-generation sequencing of 16S rDNA and metaproteomics differentiate the healthy urine microbiome from asymptomatic bacteriuria in neuropathic bladder associated with spinal cord injury. Journal of Translational Medicine, 10:174. [CrossRef]

| Properties | IC TF1 Lubricant Gel |
| Visual Appearance | White uniform, smooth and homogeneous gel |
| Gel Formation Rate | The viscosity stabilizes by 30 minutes |
| pH | ~6-7 |
| Viscosity at room temperature (RT) | ~ 13,000±2000 centipoises (cps) |
| Osmolality | ~1080-1097 at both room temperature (RT) and 37⁰C |
| Viable Lactobacilli in IC TF1 gel at the time of preparation | Log 10 CFU 10.1 ± 0.02 |
| The Effect of Temperature on Viable Lactobacilli in IC TF1 Gel | Room temperature for 24 hours, Log 10 CFU 10.2 ± 0.04 |
| Refrigeration for 24 hours, Log 10 CFU 10.0 ± 0.06 | |
| 37⁰C for 24 hours, No visible colonies | |
| Effect of Urine Media on viable Lactobacilli in IC TF1 Gel, 20-24 hours after preparation. | In the presence of Synthetic Urine Media, Log 10 CFU 9.98 ± 0.02 |
| In the presence of Human Urine Media, Log 10 CFU 10.2 ± 0.05 |
| Gel | Conditions | Time | ||
| 30 Minutesb | 4 Hours | 24 Hours | ||
| Control Gel | RTa | 1089.6 | - | - |
| IC TF1 Gel | RT | 1097.6 | 1096.6 | 1099.0 |
| 37⁰C | 1097.2 | 1086.6 | 1088.2 | |
| EZ Lubricating Jelly™ | RT | 2708 | - | - |
| HR Lubricating Jelly™ | RT | 1761.6 | - | - |
| Test Organism | Control | IC TF11 |
| E. coli | - | 12.70 mm |
| E. faecium | - | 10.16 mm |
| K. pneumoniae | - | 15.24 mm |
| P. mirabilis | - | 12.70 mm |
| C. albicans | - | 11.43 mm |
| Cell Line | Test articles | Average Grade |
| L929 mouse fibroblast cell culture Test 1 |
Control Gel | 0 |
| HR Lubricating Jelly™ | 0 | |
| L929 mouse fibroblast cell culture Test 2 |
Control Gel | 1 |
| IC TF1 Gel | 2 | |
| EZ Lubricating Jelly™ | 1 | |
| Human Urethra Epithelial Cells Test 3 |
Control Gel | 1 |
| IC TF1 Gel | 2 | |
| HR Lubricating Jelly™ | 2 |
| Treatment Group | Mean +/- SD (%) (n=3) |
| PBS | 100 ± 23.1 |
| Control gel | 111.1 ± 15.4 |
| EZ Lubricating Gel™ | 116.2 ± 8.3 |
| HR Lubricating Jelly™ | 89.1 ± 7.3 |
| IC TF1 Gel | 120.9 ± 3.2 |
Disclaimer/Publisher’s Note: The statements, opinions and data contained in all publications are solely those of the individual author(s) and contributor(s) and not of MDPI and/or the editor(s). MDPI and/or the editor(s) disclaim responsibility for any injury to people or property resulting from any ideas, methods, instructions or products referred to in the content. |
© 2024 by the authors. Licensee MDPI, Basel, Switzerland. This article is an open access article distributed under the terms and conditions of the Creative Commons Attribution (CC BY) license (http://creativecommons.org/licenses/by/4.0/).